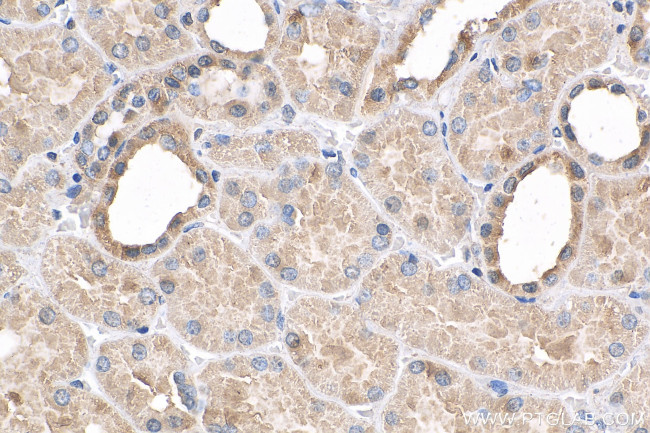
USP20 Antibody in Immunohistochemistry (Paraffin) (IHC (P))

Search
Proteintech
USP20 Polyclonal Antibody
{{$productOrderCtrl.translations['antibody.pdp.commerceCard.promotion.promotions']}}
{{$productOrderCtrl.translations['antibody.pdp.commerceCard.promotion.viewpromo']}}
{{$productOrderCtrl.translations['antibody.pdp.commerceCard.promotion.promocode']}}: {{promo.promoCode}} {{promo.promoTitle}} {{promo.promoDescription}}. {{$productOrderCtrl.translations['antibody.pdp.commerceCard.promotion.learnmore']}}
产品信息
17491-1-AP
种属反应
已发表种属
宿主/亚型
分类
类型
抗原
偶联物
形式
浓度
规格
纯化类型
保存液
内含物
保存条件
运输条件
产品详细信息
Immunogen sequence: MGDSRDLCP HLDSIGEVTK EDLLLKSKGT CQSCGVTGPN LWACLQVACP YVGCGESFAD HSTIHAQAKK HNLTVNLTTF RLWCYACEKE VFLEQRLAAP LLGSSSKFSE QDSPPPSHPL KAVPIAVADE GESESEDDDL KPRGLTGMKN LGNSCYMNAA LQALSNCPPL TQFFLECGGL VRTDKKPALC KSYQKLVSEV WHKKRPSYVV PTSLSHGIKL VNPMFRGYAQ QDTQEFLRCL MDQLHEELKE PVVATVALTE ARDSDSSDTD EKREGDRSPS EDEFLSCDSS SDRGEGDGQG RGGGSSQAET ELLIPDEAGR AISEKERMKD RKFSWGQQRT NSEQVDEDAD VD (1-351 aa encoded by BC039593)
靶标信息
SLAIN2 is closely related to SLAIN1, a novel stem cell protein that is expressed at the stem cell and epiblast stages. Unlike SLAIN1, SLAIN2 is widely expressed and is thought to play a role in regulating microtubule (MT) growth and organization. SLAIN2 binds to end-binding proteins (EBs), cytoplasmic linker proteins (CLIPs) such as CLIP170, CLIP-associated proteins, and interacts with the MT polymerase ch-TOG. Depletion of SLAIN2 using RNAi led to disorganization of the radial MT array, indicating its importance in the regulation of MT growth and organization.
仅用于科研。不用于诊断过程。未经明确授权不得转售。
生物信息学
蛋白别名: Deubiquitinating enzyme 20; hVDU2; pVHL-interacting deubiquitinating enzyme 2; Ubiquitin carboxyl-terminal hydrolase 20; ubiquitin specific protease 20; Ubiquitin thioesterase 20; ubiquitin thiolesterase 20; Ubiquitin-specific-processing protease 20; VHL-interacting deubiquitinating enzyme 2
基因别名: 1700055M05Rik; AI467231; hVDU2; KIAA1003; LSFR3A; USP20; VDU2
UniProt ID: (Human) Q9Y2K6, (Mouse) Q8C6M1
Entrez Gene ID: (Human) 10868, (Mouse) 74270, (Rat) 311856